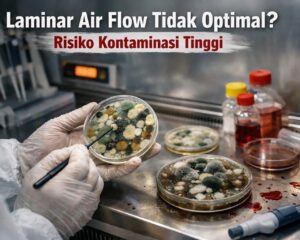

🧼 Peran Penting Laminar Air Flow dalam Laboratorium Laminar Air Flow (LAF) merupakan alat penting dalam laboratorium yang berfungsi untuk menjaga area kerja tetap steril
Read more
🧼 Peran Penting Laminar Air Flow dalam Laboratorium Laminar Air Flow (LAF) merupakan alat penting dalam laboratorium yang berfungsi untuk menjaga area kerja tetap steril
Read more